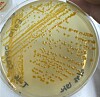

Identifican nueva bacteria en piscicultura chilena
La cepa denominada Flavobacterium maulense presenta características genéticas y fisiológicas únicas, aportando nuevos antecedentes sobre la diversidad microbiana en la salmonicultura.
Científicos chilenos aislaron y caracterizaron una nueva especie bacteriana a partir de agua utilizada en el cultivo de alevines de salmón del Atlántico en Chile, la que fue denominada Flavobacterium maulense.
Cabe recordar que el mismo equipo de investigadores el 2024 también descubrieron otra nueva bacteria del género: Flavobacterium facile.
Los expertos de la Universidad Andrés Bello, Universidad Bernardo O’Higgins y el Centro Incar2, informaron que la cepa, identificada como T-16T, presentó características distintivas como pigmentación amarilla y motilidad por deslizamiento.
En el análisis filogenético, los especialistas confirmaron que la bacteria Gram-negativa pertenece al género Flavobacterium, aunque con diferencias suficientes respecto a especies cercanas como F. tiangeerense, F. bizetiae y F. frigoritolerans, lo que respalda su clasificación como una nueva especie.
En términos fisiológicos, la bacteria mostró un crecimiento óptimo entre 18 y 25 °C, a pH neutro y sin requerimiento de sal adicional, condiciones coherentes con ambientes de agua dulce utilizados en etapas tempranas del cultivo de salmón.
Además, su perfil lipídico, composición de ácidos grasos y contenido genómico aportaron evidencia clave para su diferenciación taxonómica.
Según los autores, este hallazgo amplía el conocimiento sobre la diversidad microbiana presente en sistemas acuícolas y podría tener implicancias relevantes para la gestión sanitaria y ambiental en la salmonicultura.
“Con base en los resultados de los diferentes análisis y las diferencias encontradas con la especie más relacionada, la cepa T-16T se propone como representante de una nueva especie bacteriana Flavobacterium maulense sp. nov.”, concluyeron los científicos.
Lea el abstract el estudio titulado “Flavobacterium maulense sp. nov. isolated from water samples culturing Atlantic salmon (Salmo salar) in Chile”, aquí.

















